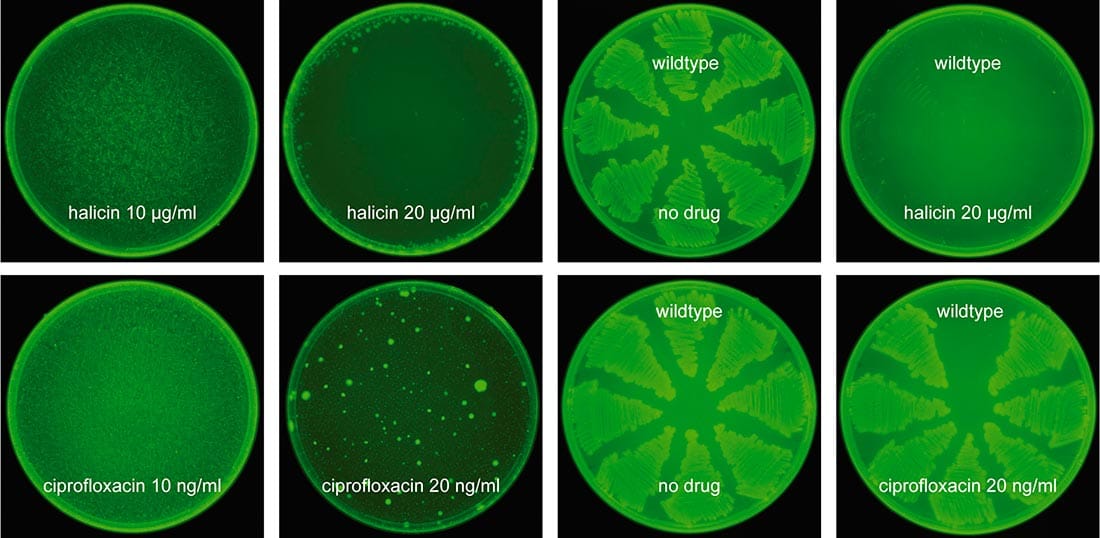

Portada »
‘HALicina’ antibiótico descubierto por una inteligencia artificial
🕒 Lectura estimada: 2 min
Portada »
🕒 Lectura estimada: 2 min
La HALicina es un antibiótico descubierto gracias a un algoritmo de aprendizaje automático o deep learning, y cuyo nombre fue inspirado en HAL, la inteligencia artificial de la película “2001: una odisea del espacio”.
Lo interesante de este nuevo paradigma médico, es que aparte de ser descubierto por una IA, la HALicina ha demostrado ser uno de los antibióticos conocidos. En pruebas de laboratorio ha demostrado una alta efectividad frente a varias superbacterias.
Para llevar a cabo este trabajo, liderado Regina Barzilay y James J. Collins, ambos en el MIT, se empezó con una base de datos de 2560 moléculas y usando una red neuronal profunda, la IA aprendió a correlaciones las estructuras atómicas y molecular de las candidatas, y luego se usó para explorar una base de datos de 6111 moléculas candidatas a fármacos para humanos.
Esto llevó a descubrir la eficacia del SU3327 que posteriormente fue bautizada como HALicina. Así mismo y con el mismo algoritmo, se ha usado para explorar 107 millones de compuestos de la base de datos ZINC15 con resultados muy prometedores y que posiblemente desemboquen en nuevos descubrimientos.
Esta nuevo forma de trabajo, es un paso gigantesco en el campo de la medicina, toda vez que los elevados costos de la investigación en este campo, desincentivan al sector privado, quienes son los que proveen los fondos para este trabajo.
La inteligencia artificial ha descubierto otros candidatos a antibióticos, pero aún están en estudio y aun falta la prueba en humanos.
james
Recibe noticias, análisis y contenido geek directo en tu bandeja.